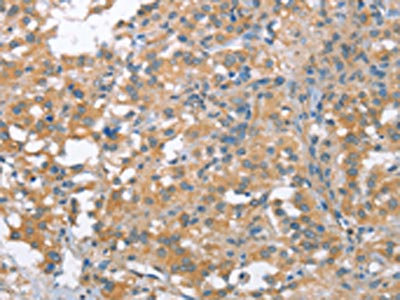

NLRP7 Antibody
-
中文名稱:NLRP7兔多克隆抗體
-
貨號(hào):CSB-PA188045
-
規(guī)格:¥1100
-
圖片:
-
The image on the left is immunohistochemistry of paraffin-embedded Human gastic cancer tissue using CSB-PA188045(NLRP7 Antibody) at dilution 1/40, on the right is treated with synthetic peptide. (Original magnification: ×200)
-
The image on the left is immunohistochemistry of paraffin-embedded Human thyroid cancer tissue using CSB-PA188045(NLRP7 Antibody) at dilution 1/40, on the right is treated with synthetic peptide. (Original magnification: ×200)
-
-
其他:
產(chǎn)品詳情
-
Uniprot No.:
-
基因名:
-
別名:CLR19.4 antibody; FLJ94610 antibody; HYDM antibody; MGC126470 antibody; MGC126471 antibody; NACHT, leucine rich repeat and PYD containing 7 antibody; NACHT, LRR and PYD containing protein 7 antibody; NACHT, LRR and PYD domains containing protein 7 antibody; NACHT, LRR and PYD domains-containing protein 7 antibody; NALP7 antibody; NALP7_HUMAN antibody; NLR family, pyrin domain containing 7 antibody; NLRP7 antibody; NOD12 antibody; Nucleotide-binding oligomerization domain protein 12 antibody; Nucleotide-binding oligomerization domain, leucine rich repeat and pyrin domain containing 7 antibody; PAN7 antibody; PYPAF3 antibody; PYRIN-containing APAF1-like protein 3 antibody
-
宿主:Rabbit
-
反應(yīng)種屬:Human
-
免疫原:Synthetic peptide of Human NLRP7
-
免疫原種屬:Homo sapiens (Human)
-
標(biāo)記方式:Non-conjugated
-
抗體亞型:IgG
-
純化方式:Antigen affinity purification
-
濃度:It differs from different batches. Please contact us to confirm it.
-
保存緩沖液:-20°C, pH7.4 PBS, 0.05% NaN3, 40% Glycerol
-
產(chǎn)品提供形式:Liquid
-
應(yīng)用范圍:ELISA,IHC
-
推薦稀釋比:
Application Recommended Dilution ELISA 1:2000-1:5000 IHC 1:50-1:200 -
Protocols:
-
儲(chǔ)存條件:Upon receipt, store at -20°C or -80°C. Avoid repeated freeze.
-
貨期:Basically, we can dispatch the products out in 1-3 working days after receiving your orders. Delivery time maybe differs from different purchasing way or location, please kindly consult your local distributors for specific delivery time.
-
用途:For Research Use Only. Not for use in diagnostic or therapeutic procedures.
相關(guān)產(chǎn)品
靶點(diǎn)詳情
-
功能:Inhibits CASP1/caspase-1-dependent IL1B secretion.
-
基因功能參考文獻(xiàn):
- Targeting the deubiquitinase STAMBP inhibits NALP7 inflammasome activity. PMID: 28492230
- we propose that rare coding variants in NLRP7 may contribute to the development of IBD. PMID: 29211899
- Though NLRP7 mutations are reported to be associated with aberrant methylation patterns at imprinted loci in the offspring of mutation carriers, negative screening results in a well-defined cohort of German women indicates that NLRP mutations are not a relevant cause of Preeclampsia. PMID: 28753543
- NLRP7 contributes to in vitro decidualization of endometrial stromal cells. PMID: 28810880
- Maternal heterozygous nonsense deletion in NLRP7 leads to recurrent reproductive failure and DNA methylation disturbances in the offspring. PMID: 28561018
- Eleven novel protein-truncating variants in NLRP7 identified in hydatidiform mole patients. Most of the breakpoints occurred within Alu repeats. PMID: 26956250
- data underscore the involvement of NLR family pyrin domain containing 7 (NLRP7) in recurrent hydatidiform mole pathophysiology and confirm that DNA methylation of specific regions is critical PMID: 26606510
- the NLRP7 inflammasome contributes to IL-1beta secretion and induction of pyroptosis in response to M. bovis infection in THP-1 macrophages. PMID: 27043315
- maternal-effect mutations of NLRP7 are associated with the most severe form of multi-locus imprinting defects in humans PMID: 26544189
- NLRP7 is involved in Hydatidiform Molar Pregnancy (HYDM1) and interacts with the transcriptional repressor ZBTB16 PMID: 26121690
- These results provide novel insights into the mechanism of NLRP7 inflammasome assembly. PMID: 26143398
- NLRP7, depending on the severity of its mutations, regulates the imprinted expression of p57KIP2 and consequently the balance between tissue differentiation and proliferation during early human development. PMID: 25097207
- NLRP7 thus appears to function in chromatin reprogramming and DNA methylation in the germline or early embryonic development.NLRP7 affects trophoblast lineage differentiation, binds to overexpressed YY1 and alters CpG methylation. PMID: 24105472
- A statistically non-significant tendency of non-synonymous variants in NLRP7 more frequent in women with familial hydatidiform mole and in women with female family members with hydatidiform mole or non-mole miscarriage. PMID: 23963444
- Two novel NLRP7-truncating mutations are associated with familial recurrent hydatidiform mole PMID: 23880596
- A SNP within NLRP7 is associated with recurrent miscarriage. PMID: 23360675
- In a Mexican population with recurrent hytadiform mole, 60% presented homozygous p.L750V mutations, 25% were compound heterozygotes for p.L750V mutation and the p.E340K variant, and 15% were heterozygous for p.E340K variant. PMID: 23354651
- Histopathological features of biparental complete hydatidiform moles in women with NLRP7 mutations. PMID: 23201303
- genetic association studies in two Egyptian families: This study expands the known cases of mutations in NLRP7 associated with recurrent hydatidiform mole. [CASE REPORT] PMID: 22770628
- Activation of NLRP7 promoted ASC-dependent caspase-1 activation, IL-1beta and IL-18 maturation, and restriction of intracellular bacterial replication, but not caspase-1-independent secretion of the proinflammatory cytokines IL-6 and tumor necrosis factor-alpha. PMID: 22361007
- NLRP7 mutations may lead to familial recurrent hydatidiform mole. PMID: 22169519
- As homozygous NLRP7 mutations are associated with recurrent hydatidiform mole or conception loss, the heterozygous state could represent a risk factor for nonrecurrent mole. PMID: 22646272
- NLRP7 mutations do not represent a major cause of complete hydatidiform moles of proven androgenetic origin. PMID: 22315435
- Data report the presence of three novel NLRP7 variants that were found only in patients with sporadic hydatidiform moles but not in 100 controls from the Senegalese general population. PMID: 21948117
- NLRP7 co-localizes with the Golgi and the microtubule-organizing center and is associated with microtubules. This suggests that NLRP7 mutations may affect cytokine secretion by interfering, directly or indirectly, with their trafficking. PMID: 22025618
- a new homozygous NLRP7 mutation in patients with recurrent hydatidiform mole PMID: 21439709
- three new protein-truncating mutations in NLRP7 are described; data suggest that patients with a single defective allele have better reproductive outcomes than patients with two defective alleles PMID: 21507883
- women with mutations in NLRP7 cannot achieve a normal pregnancy and each molar pregnancy carries risk of malignant transformation PMID: 22130487
- study of familial and sporadic recurrent hydatidiform moles; report of the first Tunisian patients: 2 sisters with homozygous NLRP7 mutations (p.E570X) and 1 sporadic case with no mutation in NLRP7 PMID: 21623199
- The presence of NLRP7 mutations was demonstrated in two patients with recurrent spontaneous abortions, and some rare non-synonymous variants (NSVs), present in the general population, were found to be associated with recurrent reproductive wastage. PMID: 21659348
- previous and current data show the association of NLRP7 mutations with several types of hydatidiform moles and with triploid spontaneous abortions PMID: 21421271
- genetic analysis of NLRP7 in 2 cases of recurrent complete hydatidiform mole: (1) patient has novel homozygous mutation in exon 8 of NLRP7; (2) patient had androgenetic CHM with no apparent mutations in NLRP7 PMID: 20870286
- the presence of two founder mutations in the Indian population (mutations have no consequences on male reproduction) PMID: 19650864
- NMR resonance assignments of the human NLRP7 PMID: 19888692
- Up-regulation of NALP7 is associated with testicular seminomas PMID: 15596043
- Stable expression of PYPAF3 (NALP7) abrogated the ability of cells to produce interleukin-1beta in response to lipopolysaccharide. PMID: 15817483
- Five mutations in the maternal gene NALP7 in individuals with familial and recurrent Hydatidiform mole PMID: 16462743
- Mutation my be involed in the inflammatory and apoptoic pathways in hydatidiform moles. PMID: 16501554
- Role of NALP7 in apoptosis and inflammation pinpoints previously unrecognized pathways that could directly or indirectly underlie the abnormal methylation of imprinted genes in hydatidiform moles tissues. PMID: 16874523
- study reports a first stop codon, c.295G>T (p.Glu99X) and a missense mutation, c.1970A>T (p.Asp657Val) in NLRP7 in two sisters with familial recurrent hydatidiform moles PMID: 17579354
- Our findings firmly establish that NLRP7 mutations are a major cause of biparental hydatidiform moles and confirm presence of a complex pattern of imprinting abnormalities in BiHM tissues. PMID: 18039680
- NLRP7 expression was positive in cancer cells in 7 cases. There was a statistical relationship between the depth of tumor invasion and NLRP7 expression. NLRP7 expression showed a trend for being associated with poor prognosis. PMID: 18751440
- Ten new mutations in NLRP7 are responsible for several types of hydatidiform moles. PMID: 19066229
- Screened a large series of women with familial recurrent hydatidiform mole. 16 different mutations were identified in the study, 13 of which were novel. PMID: 19246479
顯示更多
收起更多
-
相關(guān)疾病:Hydatidiform mole, recurrent, 1 (HYDM1)
-
蛋白家族:NLRP family
-
組織特異性:Expressed in numerous tissues including uterus and ovary, with low levels in heart and brain. Not detected in skeletal muscle.
-
數(shù)據(jù)庫鏈接:
Most popular with customers
-
-
YWHAB Recombinant Monoclonal Antibody
Applications: ELISA, WB, IHC, IF, FC
Species Reactivity: Human, Mouse, Rat
-
Phospho-YAP1 (S127) Recombinant Monoclonal Antibody
Applications: ELISA, WB, IHC
Species Reactivity: Human
-
-
-
-
-